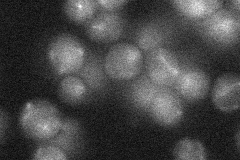
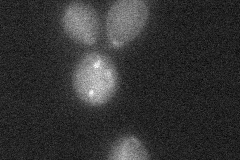

View description
Subunit of a complex, with Slx4p, that hydrolyzes 5' branches from duplex DNA in response to stalled or converging replication forks; function overlaps with that of Sgs1p-Top3p
Localization:
Intensity:
Fold change:
Significance:
-
C’ GFP library in SD

below threshold17.16 -
N' NOP1pr-GFP in SD

nucleus28.2731 -
N' TEF2pr-mCherry in SD

nucleus7.56896 -
N' NATIVEpr-GFP in SD
below threshold18.4732 -
N' TEF2pr-VC and Cyto-VN in SD
below threshold25.0727 -
C’ GFP library in SD+DTT

cytosol17.140.99No -
C’ GFP library in SD+H2O2

cytosol14.440.84No -
C’ GFP library in Starvation Media

cytosol15.210.88No -
C’ GFP library on the background of Pup2-DaMP

below threshold -
C’ GFP library on the background of CCT mutant

below threshold17.83351.03921No
